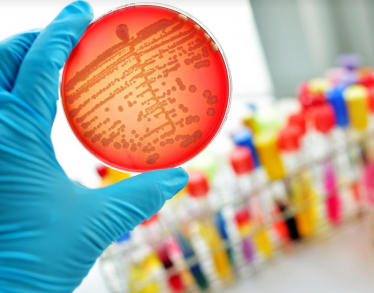

ΕΠΙΣΤΗΜΟΝΙΚΗ ΔΙΑΛΕΞΗ: "ΠΡΟΛΗΨΗ & ΑΝΤΙΜΕΤΩΠΙΣΗ ΛΟΙΜΩΞΗΣ ΑΠΟ Β-ΑΙΜΟΛΥΤΙΚΟ ΣΤΡΕΠΤΟΚΟΚΚΟ ΤΗΣ ΟΜΑΔΑΣ Β"
Με επιτυχία διεξήχθη στην Κλινική ΡΕΑ, τη Δευτέρα 10 Ιουνίου 2019, η Επιστημονική Διάλεξη με θέμα: "Πρόληψη & Αντιμετώπιση Λοίμωξης από Β-Αιμολυτικό Στρεπτόκοκκο της Ομάδας Β".
Ομιλήτρια ήταν η κα Μαρίζα Τσολιά, Καθ. Παιδιατρικής - Λοιμωξιολογίας, Διευθύντρια Β' Παιδιατρικής Κλινικής Εθνικού Καποδιστριακού Πανεπιστημίου Αθηνών, Νοσοκομείο Παίδων Π. & Α. Κυριακού.

Πρόεδροι της διάλεξης ήταν η κα Αντωνία Χαρίτου, Νεογνολόγος Παιδίατρος Εντατικολόγος, Συντονίστρια Διευθύντρια ΜΕΝΝ Κλινικής ΡΕΑ, Αντιπρόεδρος ΔΣ Ελληνικής Εταιρείας Περιγεννητικής Ιατρικής, Γεν. Γραμματέας ΔΣ Ελληνικής Νεογνολογικής Εταιρείας, Executive Committee της Union of European Neonatal & Perinatal Society και ο κος Σωτήριος Τσιόδρας, Λοιμωξιολόγος, Αν. Καθηγητής Παθολογίας Λοιμωξιολογίας Εθνικού Καποδιστριακού Πανεπιστημίου Αθηνών, Συνεργάτης Κλινικής ΡΕΑ.







